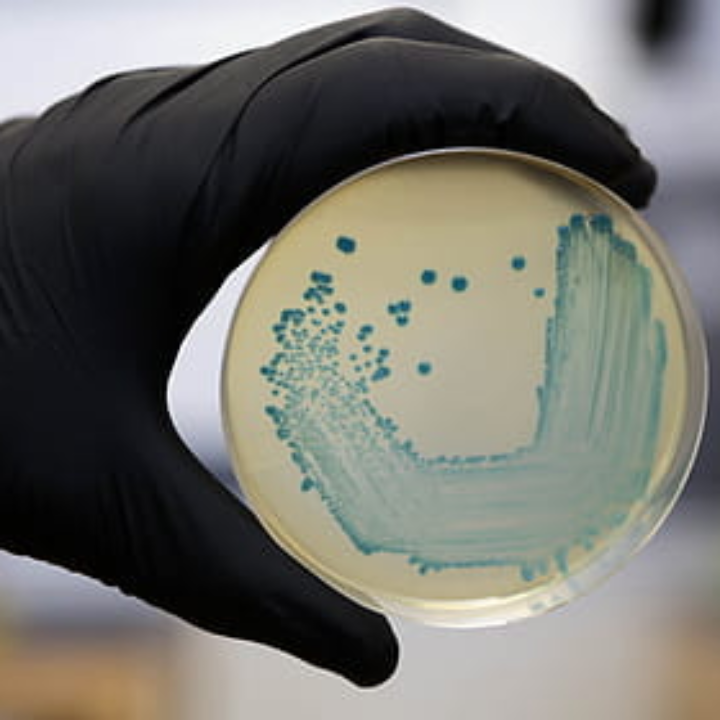
Análisis comparativo: Las mejores colonias Eugene para destacar tu estética

Análisis comparativo: Las mejores colonias Eugene para destacar tu estética
¿Estás buscando la colonia perfecta que te haga destacar y acentúe tu estética personal? ¡Llegaste al lugar indicado! Hoy vamos a hacer un análisis comparativo de las mejores colonias Eugene, conocidas por su exquisita fragancia y la durabilidad que les permite competir en un mercado tan saturado. No se trata solo de oler bien, sino de encontrar esa esencia que resuene con tu identidad y te deje una estela única.
Lo fascinante de las colonias Eugene es su combinación de ingredientes naturales y sintéticos, que les confiere un aroma único y perdurable. En este texto, exploraremos las distintas opciones que ofrece esta marca y por qué se han convertido en una elección preferida para quienes buscan no solo un perfume, sino un toque de distinción y autenticidad en cada día. ¡Vamos a sumergirnos en el mundo de las colonias Eugene y descubrir cuál se adapta a ti!
La Colonia Eugene: Un Clásico Atemporal en el Mundo de la Fragancia
En el fascinante universo de la estética y la belleza, seleccionar una colonia no es solo una cuestión de aroma, es una forma de expresar nuestra esencia y estilo personal. En Alba Centro Estética, nos complace presentarte la extraordinaria Colonia Eugene, un auténtico tesoro olfativo que ha conquistado los corazones de muchos a lo largo del tiempo.
Esta fragancia cautivadora se caracteriza por un sutil equilibrio entre frescura y elegancia, lo que la convierte en la acompañante perfecta para cualquier evento. Colonia Eugene brilla con sus notas cítricas y florales, creando una experiencia sensorial que irrumpirá en tu día a día con un toque de sofisticación y distinción.
“Con su aroma perdurable, Colonia Eugene se erige como la elección ideal para quienes desean dejar una huella única y refinada.”
Gracias a su fascinante y duradero aroma, esta colonia se presenta como una alternativa perfecta para aquellos que anhelan destacar en cualquier ocasión. En este artículo, descubrirás cómo esta fragancia puede transformarse en tu firma personal, subrayando tanto tu belleza interior como exterior con cada pulverización.
- Notas cítricas que aportan frescura.
- Toques florales que añaden elegancia.
- Aroma intenso y duradero que cautiva.
Sumérgete en el mundo de Colonia Eugene y haz que cada rociada hable de ti.
Eligiendo la Fragancia Perfecta: Un Análisis de las Colonias Eugene para Tu Rutina Estética
Al adentrarse en el ámbito de la estética, la elección de la colonia adecuada puede marcar una gran diferencia en tu rutina diaria. En este artículo, realizamos un recorrido por las mejores colonias Eugene y analizamos sus características más sobresalientes.
La colonia Eugene ha logrado mantenerse en el tiempo como una fragancia favorita, reflejando elegancia y sofisticación.
Comenzamos con Eau Jeune L’échappée Belle De Nuit, un oasis sensorial en formato de pulverizador de 75 ml, que está disponible por tan solo 10,00€. Esta fragancia cautivadora garantiza un lugar especial en el corazón de quienes buscan un toque de misterio y encanto.
Por otro lado, Pret A Porter Eau De Toilette, en su presentación de 50 ml, se ofrece a un atractivo precio de 4,20€. Ideal para quienes buscan frescura y simplicidad en su día a día sin sacrificar calidad.
Otra opción interesante es FARALA - Original, una colonia de 75 ml que se puede encontrar en el formato spray por solo 7,99€. Su esencia natural la convierte en un complemento perfecto para cualquier ocasión.
No podemos olvidar el clásico Instituto Español Gotas Frescas, un agua de colonia en presentación vaporizador de 250 ml que se puede adquirir a partir de 4,01€. Esta opción se destaca por su gran capacidad y frescura.
La Trayectoria de la Colonia Eugene
La historia de la colonia Eugene es un relato de tradición y distinción. Creada por un maestro perfumista, su objetivo ha sido encapsular una esencia que respire elegancia. Con el paso del tiempo, esta fragancia ha demostrado ser una elección perdurable para los apasionados de los perfumes.
Notas Aromáticas Esenciales
Para valorar adecuadamente la colonia Eugene, es crucial explorar las notas aromáticas que la definen. Desde las notas de salida que nos envuelven al instante, hasta las notas de fondo que persisten y nos acompañan durante horas, cada matiz cuenta. Este análisis revela la complejidad y sinfonía de esta aromática joya en cada pulverización.
Comparativa con Otras Fragancias Legendarias
En el vasto universo de la estética, muchas fragancias icónicas compiten por la atención del consumidor. Comparar la colonia Eugene con otras fragancias legendarias nos ofrece una visión clara de sus peculiaridades. ¿Qué la hace sobresalir? ¿En qué aspectos destaca y cuáles son sus áreas de mejora? Este análisis nos permitirá reconocer su valor en el mercado actual y su importancia en la industria de la perfumería.
El análisis comparativo de perfumes nos lleva a apreciar la complejidad y singularidad de cada fragancia.
La Esencia Intemporal de la Colonia Eugene
La colonia Eugene se erige como un símbolo de la elegancia clásica, habiendo conquistado el mundo de la estética durante generaciones. Creada por un prestigioso perfumista, esta fragancia busca capturar la sofisticación y el estilo en cada gota.
A lo largo de los años, la historia de esta colonia ha sido testigo de su constante popularidad, lo que nos lleva a reflexionar sobre qué aspectos la han convertido en una elección favorita entre los entusiastas de los perfumes.
“La colonia Eugene no es solo una fragancia, es un legado de elegancia.”
Su trayectoria y evolución revelan apuntes sobre su atractivo duradero. Estos son algunos de los factores que contribuyen a su permanencia en el mercado:
- ✔️ Creación por un perfumista renombrado
- ✔️ Simplicidad y complejidad de sus notas
- ✔️ Capacidad de adaptarse a tiempos modernos
Así, el viaje de la colonia Eugene a través del tiempo subraya su esencia intemporal, un recordatorio de que algunas cosas simplemente no pierden su valor con el paso de los años.
Explorando las Notas Aromáticas de la Colonia Eugene
Para entender realmente la esencia de la colonia Eugene, es esencial realizar un recorrido por sus notas aromáticas. Desde el primer instante en que toca la piel, las notas de salida nos atrapan, mientras que las notas de fondo se apoderan de la experiencia durante horas. Cada uno de estos elementos desempeña un papel fundamental en la vivencia olfativa que esta fragancia ofrece.
Adentrarse en estas notas no es solo cuestión de oler, sino de apreciar la complejidad y la armonía que subyacen en cada aplicado de este perfume exquisito.
“Cada componente es clave para captar la esencia de esta fragancia.”
Las notas de la colonia se pueden desglosar de la siguiente manera:
- Notas de Salida: Primeras impresiones que capturan la atención.
- Notas de Corazón: La identidad de la fragancia, revelándose con el tiempo.
- Notas de Fondo: Lo que perdura y deja una huella memorable.
Así, al analizar cada una de estas capas, se puede disfrutar completamente de la riqueza que la colonia Eugene tiene para ofrecer, convirtiéndola en una elección realmente especial.
Un vistazo a la colonia Eugene y su lugar en el mundo de las fragancias
En el fascinante ámbito de la perfumería, varias fragancias icónicas luchan por captar la atención de los amantes de los aromas. En este contexto, resulta enriquecedor llevar a cabo una comparativa entre la colonia Eugene y otras notablemente populares. Pero, ¿qué características la hacen resaltar frente a otras opciones clásicas? ¿Qué aspectos la convierten en una elección deseable y cuáles son sus zonas de mejora? Este análisis nos ofrece una óptica más clara sobre su posición en el mercado actual y su significado en la industria de la estética.
Características de la colonia Eugene
Para comprender mejor la esencia de la colonia Eugene, examinemos sus aspectos más destacados y sus puntos débiles. Esta fragancia ha sabido consolidarse en un entorno competitivo gracias a ciertos elementos clave:
- Notas únicas: La combinación de sus ingredientes despliega una sinfonía olfativa que no pasa desapercibida.
- Diseño de envase: Su presentación estética atrae tanto como su aroma.
- Durabilidad: Una duración prolongada en la piel que asegura una experiencia satisfactoria.
Comparativa con otras fragancias icónicas
Al poner la colonia Eugene bajo la lupa en comparación con otras grandes del mundo de las fragancias, podemos identificar algunas áreas donde brilla y otras donde podría mejorar. Con esto en mente, nos proponemos evaluar:
- Prestigio de marcas comparables: Marcas como Chanel y Dior ofrecen alternativas con gran renombre.
- Variedad de fragancias: Algunas casas perfumistas exploran un rango más amplio de aromas y estilos.
- Accesibilidad: El precio y la disponibilidad son factores esenciales para muchos consumidores.
La Singularidad de la Colonia Eugene
La colonia Eugene resalta por su originalidad y una notable durabilidad, aunque, en el vasto mundo de las fragancias de alta gama, su reconocimiento y popularidad pueden no estar a la altura de otras marcas más renombradas.
Este perfume se caracteriza por sus ingredientes esenciales, que incluyen rosas búlgaras y patchouli, los cuales le confieren una esencia única y de larga duración.
“La colonia Eugene es más que un simple aroma, es una declaración de intenciones.”
Es prudente consultar reseñas y comparativas confiables antes de decidir si la colonia Eugene se adapta a tus necesidades estéticas.
- Fragancia distintiva
- Ingredientes naturales
- Durabilidad prolongada
Así que, ¡no dudes en probarla y experimentar la elegancia que añade a tu vida!
Explora el Universo de la Estética
Hola, soy Alba y desde mis años más jóvenes ha sido un deseo ardiente el sumergirme en el fascinante ámbito de la estética y el cuidado personal. En mi plataforma, encontrarás análisis exhaustivos y recomendaciones sinceras sobre una variada gama de productos, que van desde cremas faciales hasta ingeniosos dispositivos dedicados al cuidado del cabello.
Mi propósito es claro: guiarte para que encuentres los productos que se ajusten perfectamente a tus necesidades de belleza y bienestar.
Nos especializamos en examinar y comparar los mejores productos presentes en el mercado. Esto incluye:
- Evaluaciones detalladas de cremas para el rostro
- Análisis de dispositivos para cuidar el cabello
- Recomendaciones personalizadas basadas en experiencias reales
Nuestro enfoque es ayudarte a descubrir las soluciones más adecuadas para tu cuidado personal. Cada decisión que tomes estará sustentada por nuestra experiencia y conocimientos profundos. Te invitamos a que explores nuestras guías y reseñas para transformar tu rutina de belleza y bienestar con opciones probadas y recomendadas.
Por cierto, esta web utiliza cookies para garantizar que disfrutes de la mejor experiencia al navegar. Estas pequeñas herramientas se almacenan en tu navegador y permiten funciones como:
- Reconocerte en tus visitas
- Ayudar a nuestro equipo a comprender qué secciones son más interesantes
Ten en cuenta que si decides desactivar las cookies, no podremos recordar tus preferencias. Esto significa que tendrás que configurarlas cada vez que regreses a nuestra web.
También contamos con Google Analytics, un servicio que nos ayuda a recopilar información anónima sobre aspectos como el número de visitantes y las páginas más visitadas de nuestro sitio.
FAQ - Preguntas Frecuentes
¿Qué hace a las colonias Eugene tan especiales?
Su mezcla única de ingredientes naturales y sintéticos proporciona un aroma duradero y exquisito.
¿Cómo se comparan las colonias Eugene con otras del mercado?
Destacan por su fragancia intensa y durabilidad, superando a muchas opciones convencionales.
¿Cuáles son los ingredientes clave en las colonias Eugene?
Incluyen una variedad de esencias naturales que aportan unicidad, combinadas con toques sintéticos.
¿Son las colonias Eugene aptas para todas las pieles?
Generalmente sí, pero se recomienda probar en una pequeña área si tienes piel sensible.
¿Cómo se deben aplicar para maximizar su duración?
Aplícalas en puntos de pulso como muñecas y detrás de las orejas para un efecto duradero.
¿Las colonias Eugene tienen alguna nota característica?
Sí, suelen incluir notas frescas y florales, equilibradas con acordes amaderados.
¿Son adecuadas para ocasiones formales?
Absolutamente, su sofisticación las hace perfectas para eventos elegantes.
¿Qué tamaños vienen las colonias Eugene?
Se presentan en varios tamaños, desde frascos pequeños ideales para llevar, hasta versiones grandes.
¿Son las colonias Eugene cruelty-free?
Sí, la marca se compromete con prácticas éticas y no realiza pruebas en animales.
¿Dónde se pueden comprar las colonias Eugene?
Están disponibles en tiendas de perfumes, grandes almacenes y en línea a través de su sitio web oficial.







